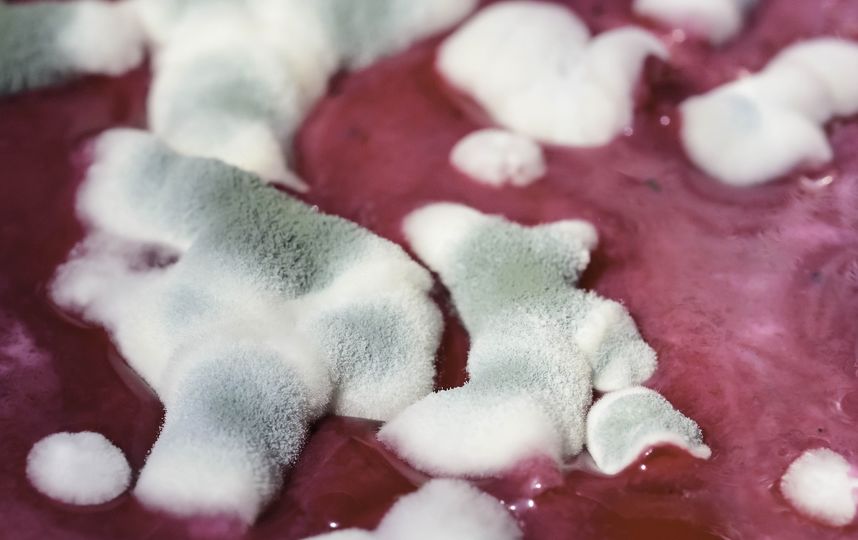
На сегодняшний день известно более 400 видов микотоксинов. Фото Pixabay

Все знают, что появление плесени на еде - признак того, что она испортилась, и есть такой продукт не просто неполезно, а, возможно, даже опасно для здоровья. Тем не менее, многие пренебрегают рекомендациями диетологов и всё равно не выбрасывают слегка заплесневевшие фрукты, овощи, хлеб или сыр. Ведь от одного кусочка ничего не будет. Или всё-таки будет?
Научное издание Naked Science опубликовало видео, в котором подробно объясняется, какой эффект оказывает заплесневевшая пища на организм.
Специалисты объясняют, что плесень на самом деле представляет собой разные виды грибов без крупных, заметных глазу плодовых тел.
При разовом попадании в организм пищи с небольшим количеством плесени здоровью в большинстве случаев ничего не грозит, особенно, если у вас хороший иммунитет. Однако у людей с аллергией на плесень такие продукты могут вызвать определенную реакцию. В медицинской практике известен один случай смерти подростка после употребления в пищу оладьев, сделанных из муки двухлетней давности, в которой была плесень.
"Другая опасность, которая таится в еде с плесенью, - микотоксины. Эти вещества появляются в плесени при определённых условиях, и они ядовиты для людей и других существ", - пояснили учёные. Отмечается, что небольшие количества могут не нанести организму вреда, однако большие дозы или употребление в течение длительного времени могут отрицательно сказаться на здоровье.
Так, афлотоксин, чаще всего встречающийся в кукурузе и арахисе, в 60-е годы “истребил” поголовье из 100 тысяч индеек в Великобритании, попав в корм птиц. У людей афлотоксин повышает риск заражения раком печени.
Другие не менее опасные формы микотоксинов - охратоксин и фумонизин. Охратоксин, который можно обнаружить в кукурузе и ячмене, поражает почки, а фумонизин, также часто встречающийся в кукурузе, может стать причиной врождённых пороков развития плода, попав в организм беременной женщины.
На сегодняшний день известно более 400 видов микотоксинов.
"Золотое правило - выкидывать еду при первых признаках появления плесени на мягких продуктах питания. Это касается хлеба, мягкого сыра, мяса и соусов", - предупреждают специалисты, поясняя, что в мягкой пище плесени, развившейся на одном участке, легче проникнуть в другие части продукта. Отмечается, что плесень разрастается с помощью маленьких нитевидных образований - гифов, которые легко распространяются внутри мягкой пищи.
В случае с твёрдой пищей - твёрдыми сырами, овощами или фруктами - можно просто вырезать пятно плесени и сполоснуть срез, так как за недолгое время она, скорее всего, не успеет проникнуть внутрь продукта.
Ещё одной опасностью пищи с плесенью является большая вероятность наличия в ней бактерий. По этой причине рекомендуетсявыбрасывать любую еду с признаками плесени.